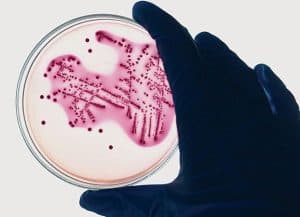

Let’s be honest, no one is really ‘destined’ to work in pharma – no one drifts of to sleep when they’re 17, dreaming of performing splash-less dives into a swimming pool of life-saving or hitherto undiscovered pharmaceuticals (with the possible exception of Keith Richards).
For those of us who make it into the inner sanctum of pharma, it is usually through a more gradual, measured and mused-upon process. But, once we arrive, the realisation blossoms that this historically mysterious industry is the only one on the planet that truly ofers a complete array of narratives – life, death and everything in between. This process of ‘demystifying’ pharma and possibly carving a career in it, is rebooting.
The pharma monolith is changing before our very eyes and the pace of progress in recent years has been astonishing – blink and you’ll miss it. This rapid metamorphosis is being largely shaped by wider society and is triggering the biggest changes to pharma and its culture in 200 years. As our industry becomes more transparent, engaged with its ‘end users’ and while surfng the giant waves of digital opportunity, it is much more realistic that people from all walks of life feel part of the equation and – in terms of drug development – part of the solution. As you’ll discover in these pages, we are looking out towards a brave and exciting new pharmaverse.
One in which pharma is becoming a refection of us – all of us. Enjoy the mag,
John Pinching editor